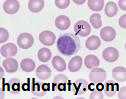
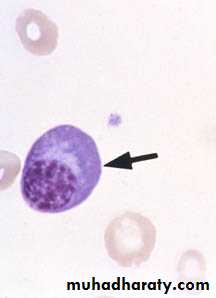
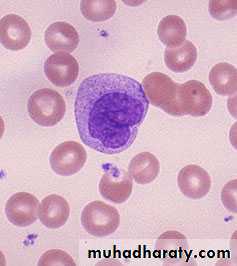

Inflammation
Lecture IIIfate of acute inflammation
Fates (outcomes) of acute inflammation
1-Complete resolution: restoration of site of acute inflammation to normal. It involve:removal of the exudate, fibrin & debris.
reversal of the microvascular changes.
regeneration of lost cells.
2-Healing & organization:connective tissue replacement. Occurs in
substantial tissue destruction.tissue cannot regenerate.
extensive fibrinous exudate.
Complete resolution
Fates (outcomes) of acute inflammation (cont.)
3-Suppuration :It may be diffuse in tissue, localized in tissue (abscess) , on the surface of a wound, or in serous cavity.
4-Progression to chronic inflammation:
Acute inflammation progress in to chronic inflammation when there is persistent infection, when there is foreign body, etc.-Ulcer
is defined as loss of continuity in an epithelial surface. or excavation of the surface of an organ or tissue produced by the sloughing of inflammatory necrotic tissue.Acute inflammation
Short duration: hours -days –weeks.Exudative fluid (protein rich fluid + inflammatory cells + debris).
Main inflammatory cellsN & Macrophage.
Chronic inflammation
Long duration: months – years.
Fibrosis.Main inflammatory cells
L, M, plasma cells + fibroblasts & endothelial cells.Chronic Inflammation
A prolonged process in which inflammation and attempt of healing proceed at the same time.
It is less uniform & productive.The main cells are mononuclear cells.
The dominant cellular player in chronic inflammation is the tissue macrophageIt is joined by lymphocytes and plasma cells,
however mast cells and eosinophils are as well involved in chronic allergic diseases
Blood monocyte
Tissue macrophage (RES)migrate into tissue
within 48 hours
after injury
and differentiate
Kupffer cell (liver)
Microglia (CNS)
Histiocytes (spleen)
Alveolar macs (lung)
Lymphocyte
Plasma cell
Chronic Inflammation
Inflammation of long duration, characterized bypredominance of lymphocytes, plasma cells & Mac.
productive (fibrous tissue) rather than exudate through formation of granulation tissue.
It may arise in 3 ways
1-Progression from acute inflammation
persistent inflammation & suppuration.
presence of indigestible endogenous (e.g dead bone), or exogenous (e.g suture).
2-Repeated episodes of acute inflammation (e.g. Chronic Cholecystitis ).
3-Primary chronic inflammation.
Causes of chronic inflammation : 1. Persistent infection by certain micro- organisms. 2. Prolonged exposure to potentially toxic agents-( exogenous or endogenous agents ) e.g. silica, asbestose ect. 3. autoimmunity e.g. rheumatoid arthritis.
Outcome of chronic inflammation
UlcersFistulas
Granulomatous diseasesFibrotic diseases (Scaring)
and combinations of the aboveMorphologic features of chronic inflammation. 1. Infiltration with, -lymphocytes -plasma cells -eosinophils -mast cells -macrophage, activated to epitheliod cells ,or fused together forming giant cell. 2. Tissue destruction. 3. Attempts of healing.
Primary chronic inflammation
No initial phase of acute inflammation e.g.,Certain infections e.g T.B, leprosy, brucellosis, viral
Prolonged exposure to potential toxic agents e.g. silica, lipids.
Foreign body reactions.
Some autoimmune diseases e.g. rheumatoid fever.
Specific diseases of unknown etiology e.g. ulcerative colitis.
Primary granulomatous diseases e.g. sarcoidosis.
Granulomatous inflammation
Special type of chronic inflammation in which the predominant cell type is an epitheloid macrophageEpitheloid macrophages: Activated macrophage that has acquired an enlarged, elongated squamous cell-like appearance. They have secretory rather than phagocytic activity
Macrophage giant cell: A large cell having numerous nuclei. 2 main types:
Foreign body GC.
Langhan’s GC.
Granuloma:
An aggregate of epitheloid macrophages.
surrounding rim of mononuclear infl cells.
surrounding rim of fibroblast & fibrosis.giant cells.
central necrosis e.g., caseating necrosis in T.B.Causes of granulomatous inflammation
Specific infectionsMycobacteria (T.B, leprosy, atypical mycrobacteria ).
Parasites (larvae, eggs & worms).
Fungi, Brucellosis, Syphilis, cat-scratch disease & Yersina.
Foreign bodies
Endogenous (keratin, necrotic bone, sodium ureate).
Exogenous (talk, silica, suture material, oil, silicon).
Chemicals
Berrylosis
Drugs
Unknown
Crohn’s disease, sarcoidosis, Wegener’s granulomatosis.
Macroscopic appearance of chronic inflammation
Chronic ulcer.Chronic abscess cavity.
Induration & fibrosis.
Thickening of the wall of the hallow viscous.
Caseous necrosis.Systemic effects of acute inflammationacute phase response
Fever (temperature > 37.8oC or >100 F)Increased pulse, blood pressure, Chills and anorexia
Leukocytosis
Neutrophilia and left shift of neutrophils points to bacterial infection
Lymphocytosis points to viral infection
Eosinophilia point to allergy or parasitic infection
Acute phase protein production in liver
fibrinogen, CRP, leads to increased ESR
Increased Erythrocyte Sedimentation Rate as a result of the presence of acute phase reactants
ESR = rate at which erythrocytes settle out of unclotted blood in one hour
Normally, Erythrocytes are very buoyant and settle slowlyErythrocytes are negatively charged and repel each other (no aggregation occurs)
In presence of acute phase reactants (fibrinogen) erythrocytes aggregate due to loss of their negative charge resulting in increased sedimentation
ESR is a widely performed test to detect occult processes and monitor inflammatory conditions
- weight loss in chronic inflammation, its due to actions of IL-1 and TNF alpha which increase catabolism in skeletal muscles, adipose tissue and the liver. - Other manifestations (increase pulse and decreased blood pressure, sweating, rigors, chills, anorexia, somnolence, and malaise). - In sepsis -DIC, hypoglycemia, cardiovascular failure (septic shock).